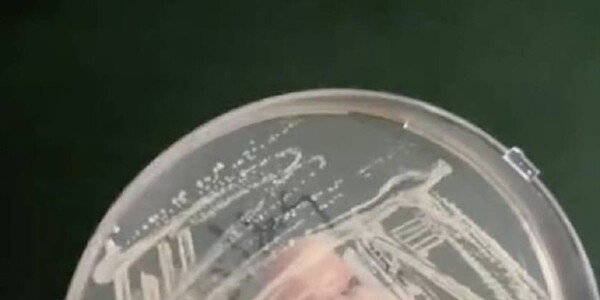

영어 공부가 치매 예방 전략이 될 수 있다고요?
두 개 이상의 언어를 사용하는 것이 뇌의 노화를 늦추고 인지 기능의 저하를 예방하는 데 도움이 된다는 연구 결과가 최근 나왔습니다. 아일랜드 트리니티 칼리지 더블린의 아구스틴 이바네즈 글로벌 뇌 건강 교수 연구팀은 유럽 27개국의 51세~90세 사이 건강한 성인 86,000명을 대상으로 다국어 사용과 노화 속도 간의 상관관계를 분석했습니다.
이 연구팀은 참가자의 실제 나이와 생물학적 나이의 차이를 계산해 노화 속도를 평가했다네요. 생물학적 나이는 심장대사 건강, 교육 수준, 인지 기능 등을 종합적으로 고려해 산출했습니다. 실제 나이보다 생물학적 나이가 낮으면 노화가 느리게 진행된다고 판단한 것이죠. 반대로 생물학적 나이가 더 높으면 가속 노화로 간주한답니다.
그 결과, “두 가지 이상의 언어를 사용하는 사람은 단일 언어의 사용자보다 가속 노화 가능성이 54% 낮은 것으로 나타났다“고 밝혔습니다. 즉, 단일 언어 사용자의 생물학적 나이가 더 많을 확률이 두 배 가까이 높다는 의미죠.
이 연구팀은 또한 “연령과 교육 수준, 신체 건강 등의 다양한 요인을 통제한 후에도 이 차이가 통계적으로 유의미하다”고 밝혔습니다. 연구팀을 이끈 이바네즈 교수는 “단 하나의 언어만 더 구사해도 가속 노화의 위험이 줄어들며, 두세 가지의 언어를 사용할 경우 그 효과는 더욱 커진다”고 설명하면서 “언어 사용이 뇌의 인지적 유연성과 회복력을 높이는 데 기여할 수 있다”고 덧붙였습니다.
이번 연구는 언어 학습이 단순한 기술 습득을 넘어, 뇌 건강과 노화 예방에 중요한 전략이 될 수 있음을 보여줍니다. 저도 노화를 늦추기 위해서라도 영어공부를 더 열심히 해야 할 이유가 하나 더 생겼네요.
|

 헬스동아
헬스동아